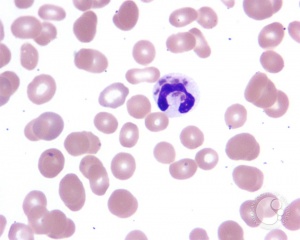

Albinism
All content on Eyewiki is protected by copyright law and the Terms of Service. This content may not be reproduced, copied, or put into any artificial intelligence program, including large language and generative AI models, without permission from the Academy.
Originating from the Latin word “albus” [1] meaning white, albinism represents a set of inherited conditions characterized by absent or decreased tissue melanin in conjunction with characteristic ocular and visual pathway anomalies. Those affected by this condition manifest varying degrees of hypopigmentation and vision-related disability. These conditions generally are incurable but are static. Proper ophthalmic and dermatologic management may be crucial in maximizing visual potential and overall prognosis. Genetic counseling for the affected individuals and their families is recommended.
Disease Entity and Epidemiology
Albinism refers to reduced pigmentation compared to others of the same racial background, with characteristic eye involvement. All races of the human species can be affected, although the phenotype is more recognizable in dark-skinned individuals. The disorder can be divided into two groups: oculocutaneous albinism (OCA)-—the most common condition among hypopigmentation disorders [2]--with varying degrees of involvement of the eyes, hair, and skin; the second group is the less common group called ocular albinism (OA) with disease involvement limited to the eyes. These heterogeneous groups of the relatively rare genetic condition affecting the tyrosine/melanin biochemical cascade are estimated to occur worldwide at a range of 1 in 5,000 to 1 in 40,000 (about 1 in 37,000 in America)[3][4]. In certain localities in Africa, however, the prevalence is estimated to be as high as 1 in 1,000 possibly as a result of consanguinity, and is a notable regional public health issue [4][5][6].
Clinical Features
A number of features in combination paint the picture of albinism.
- Iris transillumination: The iris in albinism has little to no pigment to screen out stray light coming into the eye. On slit lamp exam, the examiner may detect speckled or diffuse transillumination defect. This finding, while common with albinism, is not specific as iris transillumination occurs in diseases unrelated to albinism such as pseudoexfoliation, pigment dispersion syndrome, megalocornea, iris atrophy, and Axenfeld-Rieger spectrum [7]. When present in an otherwise normal individual, this finding may indicate carrier status of a hypomelanotic gene mutation.
The iris may be translucent and the margin of the crystalline lens may be visible on transillumunation during slit lamp examination. - Pendular nystagmus: Nystagmus refers to rhythmic, involuntary, conjugate eye movement. Affected infants may have large amplitude with low frequency pattern of eye movement starting at 2-3 months of age, later changing to a pendular form without distinct fast or slow phases. Eye muscle surgery may be considered to reduce nystagmus.
- Foveal hypoplasia (absence of a foveal pit): In albinism, the retina does not develop normally before birth and in infancy because of inappropriate retinal pigment epithelium (RPE) pigmentation that is required for macular development. Optical coherence tomography (OCT) can demonstrate an absence of the foveal pit and the loss of normal thinning of the retina. Also, the foveal avascular zone is small or nonexistent with vessels crossing the area 2 disc diameter temporal to the optic disc margin. Foveal hypoplasia is the single most important contributor to poor vision in albino patients. [7]
- Abnormal decussation of the visual pathways: Normally about half of optic nerve fibers from each eye decussates at the optic chiasm to the contralateral side, contributing to stereopsis. Albinism is associated with fiber over-decussation, resulting in crossing of up to 90% of fibers to the contralateral side and thus strabismus and loss of stereopsis. Evidence of this abnormality can be detected by 3-lead visual evoked potential (VEP) for proper counseling regarding visual potential of a patient.
- Strabismus: Misalignment of the eyes and related anomalous head tilt can occur in association with albinism. Kumar et al reported that the strabismus is seen in higher proportions of those with albinism compared to those with idiopathic infantile nystagmus, suggesting different mechanisms underlying the cause of strabismus in the two disorders. [8]
- Photophobia: Sensitivity to bright light and glare can occur due to scattering of light within the eye. Patients may prefer to wear sunglasses to reduce their sensitivity to light.
- Refractive Errors: Both myopia and hyperopia can occur, and astigmatism is very common.
- Poor vision: Vision can range from normal for those minimally affected to legal blindness or worse (vision less than 20/200) for those with more severe forms of albinism. Near vision is often better than distance vision. Generally, those who have the least amount of pigment (i.e. most severely affected) have the poorest vision.
Etiology
Oculocutaneous albinism is a group of autosomal recessive conditions associated with mutations in several enzymes or membrane proteins that contribute to melanin synthesis. The phenotype arises from a problem of melanocyte differentiation that renders synthesis or transport of melanin dysfunctional within the cells. Because the color of both skin and iris are determined by the size and number of melanosomes (organelles that contain melanin), any defect in melanin production or transport of melanosomes (intracellular vesicles that store melanin) affects skin and irig pigmentation. The phenotype in albinism depends on whether or not residual enzyme activity is present. Reduced tyrosinase activity will confer the ability to acquire pigmentation in skin, hair (white hair at birth may become blonde or reddish brown, and skin may tan), whereas patients having no tyrosinase activity will have white hair and white skin throughout their lifetime. Similarly iris color tends to fall on the spectrum from very light blue to light hazel. The severity of a patient's visual function are often dependent on the degree of nystagmus and amount of pigmentation; hence, patients with no tyrosinase activity (tyrosinase-negative oculocutaneous albinism) have poorer visual. Ocular albinism is distinguished from oculocutaneous albinism by less of skin and hair involvement, an X-linked recessive inheritance pattern, and the mutation in a distinct loci (GPR143) whose gene product is required for melanosomal maturation. A total of 15 genes are currently associated with various types of albinism[9] with as many as 729 mutations reported in the Human Gene Mutation Database associated with any of those loci[10].
Genetic Classification
Albinism has classically been organized into two broad categories, tyrosinase-positive (mild to moderate) and tyrosinas-negative (severe) albinism, based on one's phenotype rather than on genotype. With evolution of molecular genetics, finer classification according to the affected gene has dictated nomenclature of the subtypes.
There are now seven types of OCA not including the syndromes with systemic manifestations (see Differential diagnoses). All seven types are inherited in an autosomal recessive manner and are thus found in both males and females, which is in contrast to that of X-linked recessive inheritance of ocular albinism (see below). Ocular nystagmus is seen in virtually all forms of OCA[11].
OCA Type 1
This type, generally known as tyrosinase-related OCA, constitutes several subtypes that occur due to mutation in TYR gene for tyrosinase (chromosome 11q14-q21)[12]. Tyrosinase enzyme catalyzes the first two steps in the melanin biosynthesis pathway, responsible for converting tyrosine to DOPA and subsequently to DOPAquinone. Depending on differential production of the end product melanin, the severity of phenotype varies. A point mutation of TYR drives the conformation of the enzyme, which results in either absent or decreased enzyme activity. Almost 200 mutations in TYR are known to date.
- OCA 1A was formerly known as “tyrosinase-negative” albinism due characteristic absence of all pigmentation [13]. Patients affected by OCA 1A thus have the most profound phenotype of all OCAs with the greatest risk for skin cancer and highest frequency of visual symptoms and acuity loss. Hair bulbs of the affected individuals remain DOPA-negative throughout their lives, indicating that the tyrosinase activity is fully inactive (see OCA 1MP for comparison)[14]. Due to the relative severity of ocular and dermatologic problems, close ophthalmic and dermatologic care is essential.
- OCA 1B was known as the “yellow variant” due to reduced, but not absent, tyrosinase activity that produce some pigment. Patients with 1B may be indistinguishable from 1A at birth due to lack of any detectable pigment early on [7], but during the first several years of life 1B patients accumulate yellow pigment in their skin, eye, and hair. Their vision is moderately to severely reduced.
- OCA 1MP stands for “OCA 1 Mimal Pigment.” King et al in 1986[15] first proposed OCA minimal pigment as a subtype of OCA 1 by showing disordered TYR activity and clinically detectable accumulation of pigment only in the irises that increases with age. The most recent update of the definition proposed by Kono et al[16] claimed that the sites of pigment accumulation include hair and lentigo. With life-long negative DOPA staining of hair bulbs, however, 1MP phenotype contrasts with OCA 1B that has positive DOPA staining.
- OCA 1 TS is the Temperature Sensitive form that earned its name from variable tyrosinase activity depending on skin temperature. In this subtype, tyrosinase activity is inversely proportional to temperature, leading to dark hair on the cooler extremities but white hairs near the body core such as the axilla, pubic area, and scalp. As in OCA 1B, the patients can be indistinguishable at birth from OCA 1A[7].
OCA Type 2
OCA type 2 is the most common type of albinism throughout the world with the highest frequency in equatorial Africa [2]. The characteristic gene involvement for OCA2 is the OCA2 gene, previously known as P gene. OCA2 is responsible for melanosome function as it helps regulate the influx of tyrosine and other internal environment of the melanosome thus affecting the functionality of the organelle and melanin production. Of note, non-pathologic polymorphisms of the OCA2 contribute to iris colors in normal individuals [7]. This disorder is generally a milder form of OCA type 1, with cutaneous pigmentation ranging from white to fair; hair color ranging from yellow to even black; and generally milder visual dysfunction compared to OCA 1. At times the affected individual may be indistinguishable from having OCA 1B and OCA 1MP[17]. Interestingly, about 1% of patients with either Prader-Willi or Angelman syndrome are hypopigmented though often without ocular features of albinism. This phenomenon is due to the position of the OCA2 between the genes whose deletions are responsible for the two syndromes[18][19].
- OCA 2 Brown Albinism (BOCA) is a part of the clinical spectrum of OCA2. This variant of OCA 2 was initially identified in Africans of Nigerian and Ghanan ancestry and in and African Americans with light brown hair and skin[20][21] . OCA 2 patients can present anywhere between the classic phenotype (yellow/blond hair, creamy skin, blue/hazel irides) to brown-pigmentation. Affected individuals from other ethnic groups can have moderate to near-normal cutaneous pigmentation [21][22][23].
OCA Type 3
OCA 3 occurs due to a mutation in TYRP1 (tyrosinase-related protein) gene. This subtype of OCA is seen in African-born blacks but rarely in other ethnicities [24][25]. Phenotypes overlap with BOCA (see above, OCA 2) and with red/rufous OCA (ROCA) [26][7], although as the phenotype names imply, the BOCA can be differentiated from ROCA based on skin and hair color. ROCA phenotype is characterized by red-bronze skin color, ginger hair, and blue or brown irides [27]. Studies have since shown that TYRP1 contributes to melanin synthesis as well as melanocyte proliferation and apoptosis [28].
OCA Type 4
Recessive mutation in membrane-associated transport protein gene (MATP), also known as SLC45A2 , is responsible for OCA type 4. Although the gene was first identified in a Turkish patient [29], it has since been found in albino subjects in Japan and elsewhere in Europe as well. This is the third most common type of OCA after OCA2 and OCA1 [9].
OCA Type 5
A new OCA gene called OCA5 was found to be responsible for the typical OCA phenotype in a consanguinous Pakistani family[30]. This gene is mapped onto chromosome 4q24 and the genotype was designated OCA 5. Further studies on this gene are underway.
OCA Type 6
In 2013, a Chinese group of researchers, Wei et al [31] found mutations in SLC24A5 on 15q21.1 among patients of Chinese origin who presented with characteristic phenotype of non-syndromic OCA. This gene, previously studied but not linked directly to OCA phenotype, is believed to impair or disrupt melanosomal maturation [32]. OCA due to mutation in SLC24A5 gene has been since termed OCA type 6. Morice-Picard et al have since shown that this mutation is seen in different ethnic groups, indicating that the mutation is not limited to the Chinese population [33].
OCA Type 7
As the latest addition to the subtype of OCAs, OCA type 7 was identified in 2013 by Karen Grønskov and Thomas Rosenberg based on homozygosity mapping and gene sequencing of a consanguineous family with OCA symptoms on the Faroe Islands of Denmark [32]. The probands as well as unrelated but affected individuals on the island had homozygous non-sense mutation in C10orf11, a previously unknown gene that has been since shown to contribute to melanocyte differentiation. Production of OCA phenotype due to this gene mutation is thus termed OCA type 7[34].
There are two known types of ocular albinism (OA) without cutaneous involvement.
OA Type 1
Also known as Nettleship-Falls ocular albinism, this disorder is inherited in an X-linked recessive manner and thus occurs only in boys. It is the most common form of ocular albinism representing 10% of all albinism and estimated prevalence of 1 in 50,000 to 150,000 live births [35][36].
Mutations in GPR143 gene at Xp22.3-22.2 are known to be causative [37]. The affected gene codes for intracellular GPCR (G-protein coupled receptor) that controls the melanosome transport in pigment cells, disruption of which affects the number and size of the melanosomes. OA1 patients produce macromelanosomes seen on skin biopsy[7].
The clinical manifestation of OA1 depend on the ethnic background of the individual, with those who are of darkly pigmented background being less severely affected than those from light pigmentation groups [38][39]. Albinism of the eye with OA tends to be severe with poor vision. Diagnostic methods include molecular analysis of OA1 gene (GPR143), family pedigree analysis, and examination of the carrier mother. Due to lyonization of one X chromosome in each somatic cell, carrier females may exhibit evidence of speckled albinism. In up to 90% of carrier females, mud-splattered fundus is seen [40] due to the patchy dissemination of amelanotic patches of RPE among melanotic patches. Other potential findings are iris transillumination in 75%, hypopigmented macules of the skin, and biopsy evidence of macromelanosomes in those skin segments [41]. See OA2 for comparison. Of note, OA1 has been associated with late-onset sensorineural deafness (OASD)[42].The syndrome is likely the consequence of a contiguous gene defect that includes OA1 gene. OASD shares similarities but is but etiologically distinct from Waardenburg Syndrome, which is characterized by patchy depigmentation of hair and skin, heterochromia irides, and congenital deafness [43].
OA Type 2
Also known as Aland Island eye disease or Forsius-Eriksson type ocular albinism, OA2 is a rare X-linked disorder with similar clinical manifestations as OA1 with the additional protan color vision defect and defective dark adaptation. In addition to such differences, biopsy examination of skin samples from OA2 individuals revealed that OA2 is morphologically distinct from OA1 [44]. Additionally, female carriers of OA2 do not exhibit characteristic fundus pattern seen in those of OA1 carriers. Based on molecular analysis, the defective gene that gives rise to this disorder is likely in Xp21.3-p21.2 [45] for CACNA1F gene. The clinical findings, however, overlap with congenital stationary night blindness (CSNB2A). Due to similar features of OA2 and CSNB2A, Hawksworth et al raised the question of whether these two entities are the same[46].
Mutations detected in genes associated with albinism
| Full name | Abbreviation | Type | Gene/protein | Locus | Inheritance |
|---|---|---|---|---|---|
| Tyrosine negative | OCA 1A | OCA | Tyrosinase | 11q14-q21 | AR |
| Yellow variant | OCA 1B | OCA | Tyrosinase | 11q14-q21 | AR |
| Minimal pigment | OCA 1MP | OCA | Tyrosinase | 11q14-q21 | AR |
| Temperature sensitive | OCA 1TS | OCA | Tyrosinase | 11q14-q21 | AR |
| OCA Type 2 | OCA 2 | OCA | P gene / OCA2 | 15q11.2-q12 | AR |
| Brown albinism | BOCA | OCA | P gene / OCA2 | 15q11.2-q12 | 15q11.2-q12 |
| OCA Type 3 | OCA 3 / ROCA | OCA | Tyrosinase related protein (TYRP1) | 9p23 | AR |
| OCA Type 4 | OCA 4 | OCA | Membrane-associated transporter protein (MATP) = SLC45A2 | 5p13.3 | AR |
| OCA Type 5 | OCA 5 | OCA | Unknown | 4q24 | AR |
| OCA Type 6 | OCA 6 | OCA | SLC24A5 | 15q21.1 | Ar |
| OCA Type 7 | OCA 7 | OCA | C10orf11 | 10q22 | AR |
| Oculoalbinism 1 aka Nettleship-Falls ocular albinism | OA 1 | OA | GPR143 | Xp22.3 | XR |
| Oculoalbinism 2 aka Forsius-Eriksson type ocular albinism | OA 2 | OA | CACNA1F | Xp21.3-p21.2 | XR |
Differential diagnoses
The syndromic forms of albinism are associated with defects in packing and trafficking of cellular proteins, thus distinct from oculocutaneous albinism defined by the defect of melanin production[47].
Hermansky-Pudlak Syndrome (HPS)
Ocular albinism is a component of Hermansky-Pudlak Syndrome, a rare autosomal recessive disorder that is further characterized by bleeding tendency due to platelet storage deficiency, interstitial lung disease, and granulomatous colitis (depending on the subtype)[48]. HPS is believed to be due to an abnormality in the formation of intracellular vesicles such as melanosomes and the dense bodies of platelets most commonly due to a mutation in HPS1 gene on chromosome 10[7]. Because HPS is seen most commonly among those of Swiss or Puerto Rican descent at the prevalence of 1:1800[49], it should be suspected in patients with albinism with the relevant ethnic background plus the associated systemic symptoms.
Albinoidism
Albinidoism is an autosomal dominant mutation with incomplete penetrance that results in hypopigmentation. The affected patients have normal vision, retinal development, and no nystagmus. This phenotype may represent the intermediate phenotype between wild type and true albinism with macular hypoplasia [7].
Waardenburg Syndrome(WS)
WS is an autosomal dominant disorder notable for patchy areas of depigmentation of the hair and skin in piebald-like distribution, heterochromia irides (pigment abnormality of the iris), and broad nasal root. The concurrence of congenital deafness that occurs in about 20% of the patients is a distinctive noncutaneous feature of the syndrome. An estimated 2 to 35% of all congenital deafness results from WS [50] . The mutation responsible for WS occurs in the transcription factors PAX3 and MITF [51].
Chediak-Higashi Syndrome (CHS)
This rare autosomal recessive disorder boasts less than 500 reported cases in the literature in the past 20 years [52] and is among the triad of rare diseases grouped together as “silvery hair syndromes” [53]. CHS presents with variable but often intermediate form of hypopigmentation recurrent severe pyogenic infections that is ultimately lethal accompanied by progressive neurologic abnormalities, coagulation defects, and mucosal defects such as gingivitis, oral ulcerations, and periodontal diseases . The underlying defect of CHS is a mutation in the lysosomal trafficking regulator in the CHS1/LYST gene[52]. The resultant abnormal protein trafficking leads to dysfunctional fusion of vesicles and failure of transport of lysosomes to the appropriate intracellular site. The diagnosis should be considered in a young patient—many patients do not live past early childhood—presenting with OCA with the aforementioned systemic symptoms. Blood smear showing giant azurophilic granules in neutrophils, eosinophils, and other granulocytes is pathognomonic for CHS[54]. Bone marrow transplant is curative in some patients[55].
Griscelli Syndrome (GS)
Another member of the silvery hair syndrome triad, GS is a rare autosomal-recessive disorder that results in hypopigmentation of skin and hair (silver hair), neurologic deficit, with or without immunologic impairment or hematophagocytic syndrome. The severity of the diseases is determined by the involved gene-- MYO5A (GS type 1), RAB27A (GS type 2), and melanophilin (Mlph) (GS type 3). GS can be distinguished from CHS due to lack of giant intracellular granules that are seen in CHS.
Elejalde Syndrome (ES)
Not to be confused with the acrocephalopolydactylous dysplasia, also known as Elejalde syndrome, this disease entity is synonymous with Neuroectodermal melanolysosomal disease [56]. Since first reported by Elejalde in 1977 [57], ES has been reported only 10 times in the literature, suggesting a startlingly low prevalence of this disease. The phenotype of ES includes silvery hair, tendency for easy tanning due to a defect in melanin processing, profound CNS dysfunction including hypotonia, hemi or quadriplegia, seizure, and developmental delay, and lack of immunologic disturbance. More than half of the patients in the 10 reported cases are presumed to have died in childhood [56]. Microscopic evaluation of the skin aids in differentiating this disease from GS and CHS. See table below for key differences among the three Silvery Hair syndromes.
Differentiation of Syndromes with Silvery Hair
| Characteristics | Chediak-Higashi | Griscelli | Elejalde |
|---|---|---|---|
| Age at Onset | Infancy/early childhood | Infancy/early childhood | Infancy/early childhood |
| Inheritance | Autosomal recessive | Autosomal recessive | Autosomal recessive |
| Melanin in hair | Small clumps, regular pattern | Small and large clumps, irregular pattern | Small and large clumps, irregular pattern |
| Leukocytic granules | Yes | No | No |
| Recurrent infections | Yes | Yes | No |
| Neurologic impairment | Yes | Yes | Yes |
| Immune defects | Diminished chemotaxis of neutrophils, decreased natural killer function, decreased antibody dependent cellular cytotoxicity | Humoral and cell-mediated immunity disturbed | None |
| Skin light microscopy | Large melanin granules in melanocytes and keratinocytes | Hyperpigmented basal melanocytes with sparse pigmentation in adjacent keratinocytes | Irregular distribution and irregular size of melanin granules in the basal layer |
| Skin electron microscopy | Giant melanosomes in
melanocytes and keratinocytes |
Accumulation of normal-size, mature melanosomes in melanocytes, few melanosomes in keratinocytes | Melanocytes with different stages of melanosomes formation |
Management
A medical exam to evaluate for the presence of a systemic syndrome is warranted in high-risk populations or when a history of bleeding, easy bruising, or previous bacterial infections is uncovered. Patients with albinism are at higher risk for squamous cell and basal cell cancers in sun-exposed areas, and thus should be strongly encouraged to limit their sun exposure through avoiding outdoor occupations and through using sun-protective products such as appropriate clothing, large-brim hats, sunglasses, and sunscreen agents. An early eye examination is required to detect large refractive errors and to facilitate early diagnosis and management of amblyopia. Patients with strabismus or nystagmus may benefit from eye muscle surgery, so identification of such patients early may help optimize visual function. As with other heritable conditions, genetic testing and counseling support may offer invaluable support for families faced with this condition.
Investigative Treatments
- Nitisinone is an FDA-approved inhibitor of tyrosine degradation for hereditary tyrosinemia. Brooks and colleagues[58] hypothesized that the relative deficiency of tyrosinase in OCA type 1 may be ameliorated by increasing the concentration of tyrosine with nitisinone and thus improving pigmentation with OCA 1. In mice studies, nitisinone indeed improved pigmentation in fur and irides, suggesting potential for benefit in humans affected by OCA 1.
- A group by Martinez-Garcia et al [9] attempted to supplement L-DOPA, an intermediate metabolite of melanin synthesis pathway in mouse models. Various experiments suggested that L-DOPA supplementation may help overcome visual abnormalities associated with albinism[9]. Phase 2 clinical trial (link to trial) is underway in the US to study the effects of L-Dopa supplementation in human subjects[59].
- A Japanese group suggested the use of aminoglycosides that can read through non-sense mutations for a potential treatment measure for common mutations found in albinism [60].
Prognosis
Lifespan, development, intelligence, and fertility in patients with OCA are not different from unaffected patients. With proper secondary prevention and supportive care for UV protection, the risk of skin cancer may be drastically reduced [4],[61],[62],[63].
Additional Resources
- Lee, KA (2012). FocalPoints Clinical Modules for Ophthalmologists: Pediatric Diagnoses You Don't Want to Miss. American Academy of Ophthalmology. San Francisco, CA.
- Porter D, Puente MA Jr. Albinism. American Academy of Ophthalmology. EyeSmart/Eye health. https://www.aao.org/eye-health/diseases/albinism-7. Accessed November 17, 2022.
References
- ↑ Cruz-Inigo AE, Ladizinski B, Sethi A. Albinism in Africa: stigma, slaughter and awareness campaigns. Dermatol Clin. 2011 Jan;29(1):79-87
- ↑ 2.0 2.1 Lund PM. Oculocutaneous albinism in southern Africa: population structure, health and genetic care. Ann Hum Biol. 2005 Mar-Apr;32(2):168-73. Review
- ↑ Traboulsi EI, Green WR. Duane's ophthalmology; Ch. 38 An Overview of Albinism and Its Visual System Manifestations. Lippincott Williams & Wilkins. 2006.
- ↑ 4.0 4.1 4.2 Hong ES, Zeeb H, Repacholi MH. Albinism in Africa as a public health issue. BMC Public Health. 2006 Aug 17;6:212
- ↑ Berger E, Hunt R, Tzu J, Patel R, Sanchez M. Squamous-cell carcinoma in situ in a patient with oculocutaneous albinism. Dermatol Online J. 2011 Oct 15;17(10):22.
- ↑ Cruz-Inigo AE, Ladizinski B, Sethi A. Albinism in Africa: stigma, slaughter and awareness campaigns. Dermatol Clin. 2011 Jan;29(1):79-87.
- ↑ 7.0 7.1 7.2 7.3 7.4 7.5 7.6 7.7 7.8 7.9 Levin AV, Stroh E. Albinism for the busy clinician. J AAPOS. 2011 Feb;15(1):59-66.
- ↑ Kumar A, Gottlob I, McLean RJ, Thomas S, Thomas MG, Proudlock FA. Clinical and oculomotor characteristics of albinism compared to FRMD7 associated infantile nystagmus. Invest Ophthalmol Vis Sci. 2011 Apr 8;52(5):2306-13.
- ↑ 9.0 9.1 9.2 9.3 Mártinez-García M, Montoliu L. Albinism in Europe. J Dermatol. 2013 May;40(5):319-24.
- ↑ Cooper DN, Ball EV, Krawczak M. The human gene mutation database. Nucleic Acids Res. 1998 Jan 1;26(1):285-7.
- ↑ Hornyak TJ. The developmental biology of melanocytes and its application to understanding human congenital disorders of pigmentation. Adv Dermatol. 2006;22:201-18.
- ↑ Boissy RE, Nordlund JJ. Molecular basis of congenital hypopigmentary disorders in humans: a review. Pigment Cell Res. 1997 Feb-Apr;10(1-2):12-24.
- ↑ RGiebel LB, Musarella MA, Spritz RA. A nonsense mutation in the tyrosinase gene of Afghan patients with tyrosinase negative (type IA) oculocutaneous albinism. J Med Genet. 1991 Jul;28(7):464-7.
- ↑ Grønskov K, Ek J, Brondum-Nielsen K. Oculocutaneous albinism. Orphanet J Rare Dis. 2007 Nov 2;2:43.
- ↑ King RA, Wirtschafter JD, Olds DP, Brumbaugh J. Minimal pigment: a new type of oculocutaneous albinism. Clin Genet. 1986 Jan;29(1):42-50.
- ↑ Kono M, Kondo T, Ito S, Suzuki T, Wakamatsu K, Ito S, Tomita Y. Genotype analysis in a patient with oculocutaneous albinism 1 minimal pigment type. Br J Dermatol. 2012 Apr;166(4):896-8.
- ↑ Spritz RA, Oh J, Fukai K, Holmes SA, Ho L, Chitayat D, France TD, Musarella MA, Orlow SJ, Schnur RE, Weleber RG, Levin AV. Novel mutations of the tyrosinase (TYR) gene in type I oculocutaneous albinism (OCA1). Hum Mutat. 1997;10(2):171-4.
- ↑ Fridman C, Hosomi N, Varela MC, Souza AH, Fukai K, Koiffmann CP. Angelman syndrome associated with oculocutaneous albinism due to an intragenic deletion of the P gene.Am J Med Genet A. 2003 Jun 1;119A(2):180-3.
- ↑ Nicholls RD, Bailin T, Mascari MJ, Butler MG, Spritz RA. Hypopigmentation in the Prader-Willi syndrome correlates with P gene deletion but not with haplotype of the hemizygous P allele. Am J Hum Genet. 1996;59:A39.
- ↑ King RA, Creel D, Cervenka J, Okoro AN, Witkop CJ. Albinism in Nigeria with delineation of new recessive oculocutaneous type. Clin Genet. 1980 Apr;17(4):259-70.
- ↑ 21.0 21.1 King RA, Lewis RA, Townsend D, Zelickson A, Olds DP, Brumbaugh J. Brown oculocutaneous albinism. Clinical, ophthalmological, and biochemical characterization. Ophthalmology. 1985 Nov;92(11):1496-505.
- ↑ King RA, Rich SS. Segregation analysis of brown oculocutaneous albinism. Clin Genet. 1986;29:496–501.
- ↑ Manga P, Kromberg J, Turner A, Jenkins T, Ramsay M. In Southern Africa, brown oculocutaneous albinism (BOCA) maps to the OCA2 locus on chromosome 15q: P-gene mutations identified. Am J Hum Genet. 2001;68:782–7.
- ↑ Zhang KH, Li Z, Lei J, Pang T, Xu B, Jiang WY, Li HY. Oculocutaneous albinism type 3 (OCA3): analysis of two novel mutations in TYRP1 gene in two Chinese patients. Cell Biochem Biophys. 2011 Dec;61(3):523-9.
- ↑ Rooryck C, Morice-Picard F, Elçioglu NH, Lacombe D, Taieb A, Arveiler B. Molecular diagnosis of oculocutaneous albinism: new mutations in the OCA1-4 genes and practical aspects. Pigment Cell Melanoma Res. 2008 Oct;21(5):583-7.
- ↑ Kromberg JG, Castle DJ, Zwane EM, Bothwell J, Kidson S, Bartel P, Phillips JI, Jenkins T. Red or rufous albinism in southern Africa. Ophthalmic Paediatr Genet. 1990 Sep;11(3):229-35.
- ↑ Manga P, Kromberg JG, Box NF, Sturm RA, Jenkins T, Ramsay M. Rufous oculocutaneous albinism in southern African Blacks is caused by mutations in the TYRP1 gene. Am J Hum Genet. 1997 Nov;61(5):1095-101.
- ↑ Jimbow K. Biological role of tyrosinase-related protein and its relevance to pigmentary disorders (vitiligo vulgaris). J Dermatol. 1999 Nov;26(11):734-7.
- ↑ Newton JM, Cohen-Barak O, Hagiwara N, Gardner JM, Davisson MT, King RA, Brilliant MH. Mutations in the human orthologue of the mouse underwhite gene (uw) underlie a new form of oculocutaneous albinism, OCA4. Am J Hum Genet. 2001 Nov;69(5):981-8.
- ↑ Kausar T, Bhatti MA, Ali M, Shaikh RS, Ahmed ZM. OCA5, a novel locus for non-syndromic oculocutaneous albinism, maps to chromosome 4q24. Clin Genet. 2013 Jul;84(1):91-3.
- ↑ Wei AH, Zang DJ, Zhang Z, Liu XZ, He X, Yang L, Wang Y, Zhou ZY, Zhang MR, Dai LL, Yang XM, Li W. Exome sequencing identifies SLC24A5 as a candidate gene for nonsyndromic oculocutaneous albinism. J Invest Dermatol. 2013 Jul;133(7):1834-40.
- ↑ 32.0 32.1 Grønskov K, Dooley CM, Østergaard E, Kelsh RN, Hansen L, Levesque MP, Vilhelmsen K, Møllgård K, Stemple DL, Rosenberg T. Mutations in c10orf11, a melanocyte-differentiation gene, cause autosomal-recessive albinism.Am J Hum Genet. 2013 Mar 7;92(3):415-21
- ↑ Morice-Picard F, Lasseaux E, François S, Simon D, Rooryck C, Bieth E, Colin E, Bonneau D, Journel H, Walraedt S, Leroy BP, Meire F, Lacombe D, Arveiler B. SLC24A5 Mutations Are Associated with Non-Syndromic Oculocutaneous Albinism. J Invest Dermatol. 2013 Aug 28.
- ↑ Montoliu L, Grønskov K, Wei AH, Martínez-García M, Fernández A, Arveiler B, Morice-Picard F, Riazuddin S, Suzuki T, Ahmed ZM, Rosenberg T, Li W. Increasing the complexity: new genes and new types of albinism. Pigment Cell Melanoma Res. 2013 Sep 21.
- ↑ Rosenberg T, Schwartz M. X-linked ocular albinism: prevalence and mutations--a national study. Eur J Hum Genet. 1998;6(6):570.
- ↑ van Dorp DB. Albinism, or the NOACH syndrome (the book of Enoch c.v. 1-20). Clin Genet. 1987;31(4):228.
- ↑ Bassi MT, Schiaffino MV, Renieri A, De Nigris F, Galli L, Bruttini M, Gebbia M, Bergen AA, Lewis RA, Ballabio A. Cloning of the gene for ocular albinism type 1 from the distal short arm of the X chromosome. Nat Genet. 1995 May;10(1):13-9.
- ↑ O'Donnell FE Jr, Green WR, Fleischman JA, Hambrick GW. X-linked ocular albinism in Blacks. Ocular albinism cum pigmento. Arch Ophthalmol. 1978;96(7):1189.
- ↑ Shiono T, Tsunoda M, Chida Y, Nakazawa M, Tamai M. X linked ocular albinism in Japanese patients. Br J Ophthalmol. 1995;79(2):139.
- ↑ Lang GE, Rott HD, Pfeiffer RA. X-linked ocular albinism. Characteristic pattern of affection in female carriers. Ophthalmic Paediatr Genet. 1990 Dec;11(4):265-71
- ↑ Schnur RE, Gao M, Wick PA, Keller M, Benke PJ, Edwards MJ, Grix AW, Hockey A, Jung JH, Kidd KK, Kistenmacher M, Levin AV, Lewis RA, Musarella MA, Nowakowski RW, Orlow SJ, Pagon RS, Pillers DA, Punnett HH, Quinn GE, Tezcan K, Wagstaff J, Weleber RG. OA1 mutations and deletions in X-linked ocular albinism. Am J Hum Genet. 1998 Apr;62(4):800-9.
- ↑ Winship IM, Babaya M, Ramesar RS. X-linked ocular albinism and sensorineural deafness: linkage to Xp22.3. Genomics. 1993 Nov;18(2):444-5.
- ↑ Dourmishev AL, Dourmishev LA, Schwartz RA, Janniger CK. Waardenburg syndrome. Int J Dermatol. 1999;38(9):656.
- ↑ O'Donnell FE, Green WR, McKusick VA, Forsius H, Eriksson AW. Forsius-Eriksson syndrome: its relation to the Nettleship-Falls X-linked ocular albinism. Clin Genet. 1980 Jun;17(6):403-8.
- ↑ Pillers DA, Towbin JA, Chamberlain JS, Wu D, Ranier J, Powell BR, McCabe ER. Deletion mapping of Aland Island eye disease to Xp21 between DXS67 (B24) and Duchenne muscular dystrophy. Am J Hum Genet. 1990 Nov;47(5):795-801
- ↑ Hawksworth NR, Headland S, Good P, Thomas NS, Clarke A. Aland island eye disease: clinical and electrophysiological studies of a Welsh family. Br J Ophthalmol. 1995 May;79(5):424-30.
- ↑ Scheinfeld NS. Syndromic albinism: a review of genetics and phenotypes. Dermatol Online J. 2003 Dec;9(5):5.
- ↑ Seward SL Jr, Gahl WA. Hermansky-Pudlak syndrome: health care throughout life. Pediatrics. 2013 Jul;132(1):153-60.
- ↑ Wildenberg SC, Oetting WS, Almodóvar C, Krumwiede M, White JG, King RA. A gene causing Hermansky-Pudlak syndrome in a Puerto Rican population maps to chromosome 10q2. Am J Hum Genet. 1995;57(4):755–765
- ↑ Nayak CS, Isaacson G. Worldwide distribution of Waardenburg syndrome. Ann Otol Rhinol Laryngol. 2003;112(9 Pt 1):817.
- ↑ [1]Potterf SB, Furumura M, Dunn KJ, Arnheiter H, Pavan WJ. Transcription factor hierarchy in Waardenburg syndrome: regulation of MITF expression by SOX10 and PAX3. Hum Genet. 2000 Jul;107(1):1-6.
- ↑ 52.0 52.1 Kaplan J, De Domenico I, Ward DM. Chediak-Higashi syndrome. Curr Opin Hematol. 2008 Jan;15(1):22-9.
- ↑ Reddy RR, Babu BM, Venkateshwaramma B, Hymavathi Ch. Silvery hair syndrome in two cousins: Chediak-Higashi syndrome vs Griscelli syndrome, with rare associations. Int J Trichology. 2011 Jul;3(2):107-11.
- ↑ Antunes H, Pereira A, Cunha I. Chediak-Higashi syndrome: pathognomonic feature. Lancet. 2013 Nov 2;382(9903):1514.
- ↑ Karim MA, Suzuki K, Fukai K, Oh J, Nagle DL, Moore KJ, Barbosa E, Falik-Borenstein T, Filipovich A, Ishida Y, Kivrikko S, Klein C, Kreuz F, Levin A, Miyajima H, Regueiro J, Russo C, Uyama E, Vierimaa O, Spritz RA. Apparent genotype-phenotype correlation in childhood, adolescent, and adult Chediak-Higashi syndrome. Am J Med Genet. 2002 Feb 15;108(1):16-22.
- ↑ 56.0 56.1 Ivanovich J, Mallory S, Storer T, Ciske D, Hing A. 12-year-old male with Elejalde syndrome (neuroectodermal melanolysosomal disease). Am J Med Genet. 2001 Feb 1;98(4):313-6.
- ↑ Elejalde B, Valencia A, Gilbert E, Marin G, Molina J, Holguin J. 1977. Neuro-ectodermal melanolysosomal disease: An autosomal recessive pigment mutation in man. Am J Hum Genet 29: 39A.
- ↑ Onojafe IF, Adams DR, Simeonov DR, Zhang J, Chan CC, Bernardini IM, Sergeev YV, Dolinska MB, Alur RP, Brilliant MH, Gahl WA, Brooks BP. Nitisinone improves eye and skin pigmentation defects in a mouse model of oculocutaneous albinism. J Clin Invest. 2011 Oct;121(10):3914-23.
- ↑ Lavado A, Jeffery G, Tovar V, de la Villa P, Montoliu L. Ectopic expression of tyrosine hydroxylase in the pigmented epithelium rescues the retinal abnormalities and visual function common in albinos in the absence of melanin. J Neurochem. 2006 Feb;96(4):1201-11.
- ↑ K. Fukai, H. Kunimoto, K. Nakajima, T. Suzuki, M. Ishii. In vitro analysis of read-through effect of aminoglycosides to tyrosinase R278X nonsense mutation in melan-c cells. The 24th Annual Meeting of the Japanese Society for Pigment Cell Research (JSPCR-2012) 19 OCT 2012
- ↑ Ramalingam VS, Sinnakirouchenan R, Thappa DM: Malignant transformation of actinic keratoses to squamous cell carcinoma in an albino. Indian J Dermatol 2009, 54:46-48.
- ↑ Okoro AN: Albinism in Nigeria. A clinical and social study. Br J Dermatol 1975, 92:485-492.
- ↑ Chalya PL, Gilyoma JM, Kanumba ES, Mawala B, Masalu N, Kahima JK, Rambau P: Dermatological malignancies at a University Teaching Hospital in north-western Tanzania: a retrospective review of 154 cases. Tanzania Journal of Health Research 2021, 14(1):1-7.